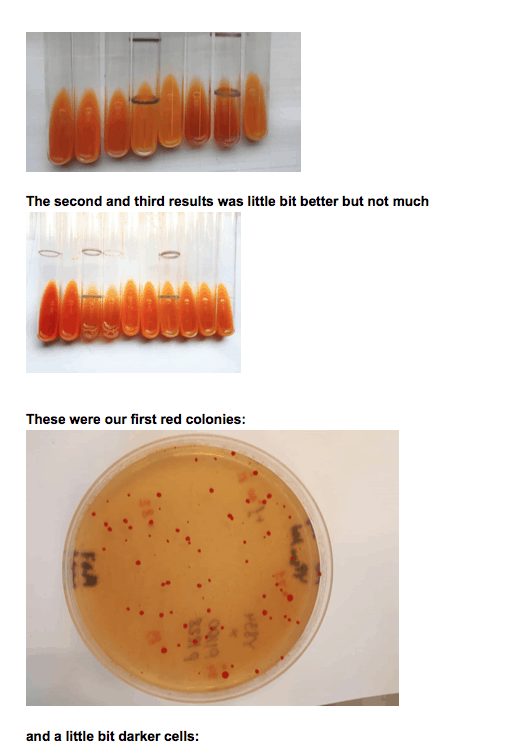

By Maxim Mikheev, PhD, CEO of BIOMEDICAN
BIOMEDICAN entered into the Astaxanthin market to diversify its products and show that its biosynthesis platform can target any high-value compound that has a significant market. We needed to do something new so that we weren’t overly concentrated on just the cannabinoid market. We analyzed what we had in search for the next big compound. Sometimes you have a valuable asset but even don’t recognize it.
After several days of intense research, we found that we had a strain producing beta-carotene with very high yield. After a not-too-long analysis, we found that by adding just a few genes, we could convert beta-carotene into Astaxanthin. Now, we’re able to produce a biosynthesized, non-GMO, and organic Astaxanthin molecule that is identical to what is found in nature.
Astaxanthin is a high-value compound. It is the strongest natural antioxidant in the world. It is 6000 times stronger than vitamin C and 550 times stronger than Vitamin E. Astaxanthin’s estimated market was $1 billion in 2019.

The Astaxanthin market consists of fish feed, animal feed, and human consumption. Astaxanthin is heavily used for salmon farming. Wild salmon has a pink color due to the presence of Astaxanthin inside. Astaxanthin is naturally produced by some alga, yeasts, and bacteria. Then zooplankton, krill, and shrimps consume the initial Astaxanthin producers. Later, salmon eat krill and shrimps, accumulate Astaxanthin, and get their pink color in the natural environment.
Astaxanthin is necessary to maintain natural color for farmed salmon. In order for farmed salmon to have the same pink color as salmon found in the wild, they must be fed Astaxanthin. This compound also serves as a chicken food supplement, adding a deep yellow color to egg yolks.
Human consumption of Astaxanthin in the form of nutraceuticals is also being used to prevent the occurrence of chronic diseases, improve health, and delay the aging process. With the growing interests in the field of dermatology, Astaxanthin’s benefits in skin homeostasis, such as antioxidant, photoprotective, and anti-inflammatory effects, have been proposed.
Consumer spending on various personal care and cosmetic products, coupled with a growing consciousness regarding nutraceuticals, will drive the Astaxanthin industry’s growth. Astaxanthin is gaining approval and suitability by numerous wellness spa service providers and cosmetics producers, owing to its skin-friendly and antioxidant properties. The human consumption market was estimated at $880 million in 2016.

Salmon farms are currently using a chemically synthetic Astaxanthin. Synthetic Astaxanthin is not identical to natural Astaxanthin.

Synthetic Astaxanthin has a different molecular shape (stereoisomers) than its natural counterpart.

The natural Astaxanthin contains the only all-trans form. There are 3 main forms (3S, 3’S), (3R, 3’R), (3R, 3’S), with the most dominant being (3S, 3’S).
Synthetic Astaxanthin contains more than 500 stereoisomers.
The current regulations have forbidden direct consumption of synthetic Astaxanthin by humans, but it is permitted to use as animal/fish feed. It was shown that synthetic Astaxanthin has no health benefits and significantly weaker antioxidant properties.
We decided to produce a natural form of Astaxanthin using biosynthesis. Biosynthesis of Astaxanthin eliminates the production of undesirable stereoisomers, allowing for the specific creation of Astaxanthin found in nature. The process works through proprietary yeasts that undergo fermentation to consistently produce large quantities of high-quality biosynthetic Astaxanthin, identical to its natural counterpart, at the same economical price as chemical synthesis.
We made an analysis of gene and some standard genetic designs last March. We ordered a gene synthesis by Twist Bioscience. One month later we received a set of constructed genes optimal for biosynthesized Astaxanthin.
Our initial results were not very good (Yellow/orange is beta-carotene. Red is Astaxanthin.)

As a summary, from the beginning (Apr 2020) to a production-ready strain (Sep 2020) took six months.
In conclusion BIOMEDICAN can produce a biosynthesized Astaxanthin product that is non-GMO, organic, and identical to what is found in nature. We can do this at 90% less cost than the current chemically synthetic product. The chemically synthetic product is less than ideal because it produces byproducts, toxins, and contaminants. Thus, there is great interest in biosynthesized Astaxanthin. The largest buyers of Astaxanthin are looking to change from chemically synthetic products to non-GMO and organic products that are significantly more bioavailable for humans and animal feed.
Maxim Mikheev, PhD, is CEO and Founder of BIOMEDICAN, a biotech startup designing patented low-cost methods of growing high-value compounds at scale with proprietary yeasts.
The Editorial Team at Healthcare Business Today is made up of experienced healthcare writers and editors, led by managing editor Daniel Casciato, who has over 25 years of experience in healthcare journalism. Since 1998, our team has delivered trusted, high-quality health and wellness content across numerous platforms.
Disclaimer: The content on this site is for general informational purposes only and is not intended as medical, legal, or financial advice. No content published here should be construed as a substitute for professional advice, diagnosis, or treatment. Always consult with a qualified healthcare or legal professional regarding your specific needs.
See our full disclaimer for more details.







1 thought on “How We Used Biosynthesis to Produce the World’s Strongest Antioxidant”
Comments are closed.